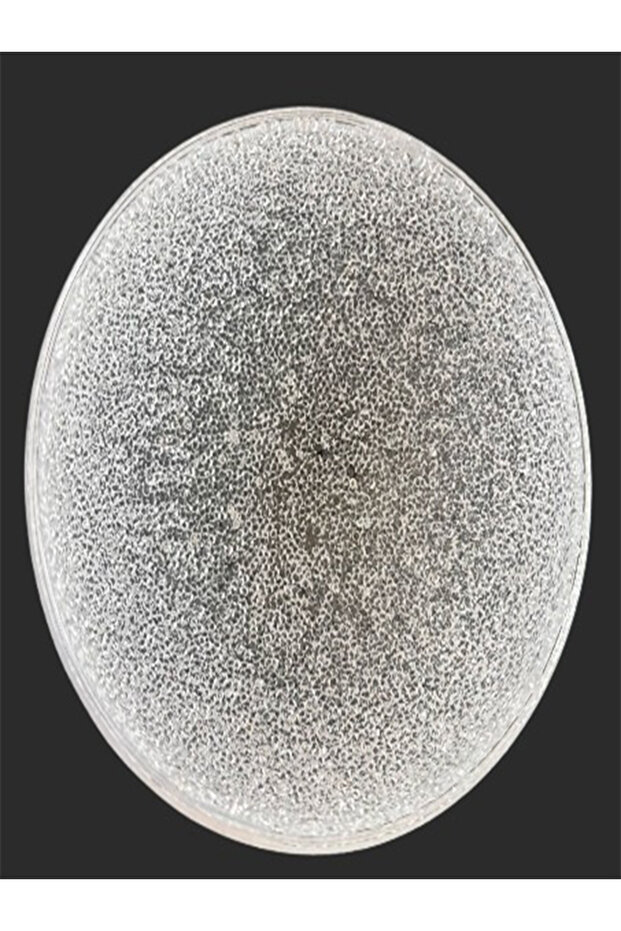
10 cm Şekerlik Top - 1

İstanbul Avize 10 cm Şekerlik Top
299 TL
Ek Hizmetler
Öne Çıkan Özellikler:
İstanbul Avize 10 cm Şekerlik Top Özellikleri
Materyal
Plastik
Ampül Başlık Sayısı
1
Model
Modern
Duy Tipi
G9
Renk
Krem
Yükseklik
20-37 cm
Kullanım Alanı
Salon / Oturma Odası
Menşei
TR
Ürün Bilgileri

İstanbul Avize 10 cm Şekerlik Top Özellikleri
Materyal
Plastik
Ampül Başlık Sayısı
1
Model
Modern
Duy Tipi
G9
Renk
Krem
Yükseklik
20-37 cm
Kullanım Alanı
Salon / Oturma Odası
Menşei
TR
Özellik
Enerji Tasarrufu
Güvenlik Bilgileri
Ürün Güvenliği Bilgileri